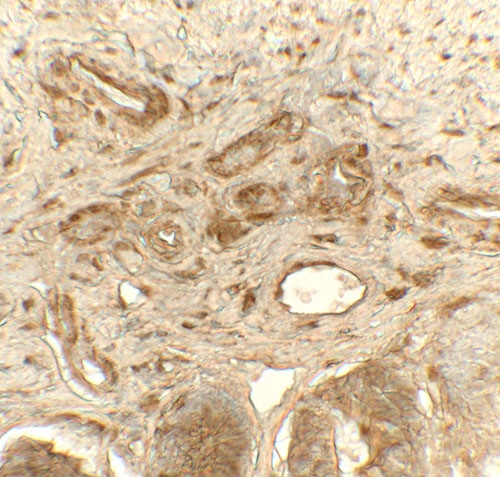

> Antigen, Antibodies, ELISA, Western Blot > Primary Antibody > Polyclonal Antibodies > PDIA1 AntibodyBrand |
Leading Biology | Catalog Number |
APR09010G |
Product Type |
Polyclonal Antibodies | Field of Research |
|
Product Overview |
We constantly strive to ensure we provide our customers with the best antibodies. As a result of this work we offer this antibody in purified format.
We are in the process of updating our datasheets. If you have any questions regarding this update, please feel free to contact our technical support team.
This product is a high quality PDIA1 antibody.
|
||
Molecular Weight |
Predicted: 54 kDa; Observed: 54 kDa
|
||
Cellular Localization |
Antigen Cellular Localization:
Endoplasmic reticulum lumen. Melanosome. Cell membrane; Peripheral membrane protein. Note=Highly abundant. In some cell types, seems to be also secreted or associated with the plasma membrane, where it undergoes constant shedding and replacement from intracellular sources (Probable). Localizes near CD4-enriched regions on lymphoid cell surfaces. Identified by mass spectrometry in melanosome fractions from stage I to stage IV.
|
||
Host |
Rabbit
|
||
Species Reactivity |
Human, Mouse, Rat
|
||
Target |
P4HB; PDIA1 antibody is human, mouse and rat reactive.
|
||
Isotype |
IgG
|
||
Symbol |
ERBA2L, PDI, PDIA1, PO4DB
|
||
GeneID |
|||
UniProt ID |
|||
Function |
This multifunctional protein catalyzes the formation, breakage and rearrangement of disulfide bonds. At the cell surface, seems to act as a reductase that cleaves disulfide bonds of proteins attached to the cell. May therefore cause structural modifications of exofacial proteins. Inside the cell, seems to form/rearrange disulfide bonds of nascent proteins. At high concentrations, functions as a chaperone that inhibits aggregation of misfolded proteins. At low concentrations, facilitates aggregation (anti-chaperone activity). May be involved with other chaperones in the structural modification of the TG precursor in hormone biogenesis. Also acts a structural subunit of various enzymes such as prolyl 4-hydroxylase and microsomal triacylglycerol transfer protein MTTP.
|
||
Summary |
PDIA1 (protein disulfide isomerase family A member 1) is the beta subunit of prolyl 4-hydroxylase, a highly abundant multifunctional enzyme that belongs to the protein disulfide isomerase family. When present as a tetramer consisting of two alpha and two beta subunits, this enzyme is involved in hydroxylation of prolyl residues in preprocollagen (1,2). PDIA1 is also a disulfide isomerase containing two thioredoxin domains that catalyze the formation, breakage and rearrangement of disulfide bonds (3). Other known functions include its ability to act as a chaperone that inhibits aggregation of misfolded proteins in a concentration-dependent manner, its ability to bind thyroid hormone, its role in both the influx and efflux of S-nitrosothiol-bound nitric oxide, and its function as a subunit of the microsomal triglyceride transfer protein complex (4).
|
||
Form |
Liquid |
||
Storage & Stability |
Store at +4°C short term. For long-term storage, aliquot and store at -20°C or below. Stable for 12 months at -20°C. Avoid repeated freeze-thaw cycles.
|
||
Applications |
WB, IHC, IF, E
|
||
Images |

Western blot analysis of PDIA1 in rat small intestine tissue lysate with PDIA1 antibody at (A) 1 and (B) 2 μg/ml.
Immunohistochemistry of PDIA1 in rat small intestine tissue with PDIA1 antibody at 5 μg/mL. 
Immunofluorescence of PDIA1 in rat small intestine tissue with PDIA1 antibody at 20 μg/mL. |
||
Specification |
|||
Quantity |
|
||
| Select | Brand | Catalog No. | Product Name | Pack Size | Type | Field of Research | Specification | Quantity | Price(USD) | |
| 1 | Leading Biology | APR03440G | ITGA11 Antibody (N-term) | 100 μl | Polyclonal Antibodies |
|
$495.00 | Add Ask | ||
| 2 | Leading Biology | APR04537G | CMIP Antibody (C-term) | 100 μl | Polyclonal Antibodies |
|
$495.00 | Add Ask | ||
| 3 | Leading Biology | APR12422G | Human H4 Histamine Receptor (extracellular) Antibody | 50 μl | Polyclonal Antibodies |
|
$695.00 | Add Ask | ||
| 4 | Leading Biology | APR03844G | UBE2W Antibody (C-term) | 100 μl | Polyclonal Antibodies |
|
$495.00 | Add Ask | ||
| 5 | Leading Biology | APR04349G | HECTD2 Antibody (N-term) | 100 μl | Polyclonal Antibodies |
|
$495.00 | Add Ask | ||
| 6 | Leading Biology | APR03502G | IGHG1 Antibody (Center) | 100 μl | Polyclonal Antibodies |
|
$495.00 | Add Ask |
 Leading Biology Inc.
2600 Hilltop DR, Building G, B Suite C138
Richmond, CA, 94806
Tel: 1-661-524(LBI)-0262
Email: info@leadingbiology.com
Leading Biology Inc.
2600 Hilltop DR, Building G, B Suite C138
Richmond, CA, 94806
Tel: 1-661-524(LBI)-0262
Email: info@leadingbiology.com
Complete this form and click send to ask us a question, request a quote or simply say hello.

You have 0 item in your cart

You have 0 item in your inquiry list
